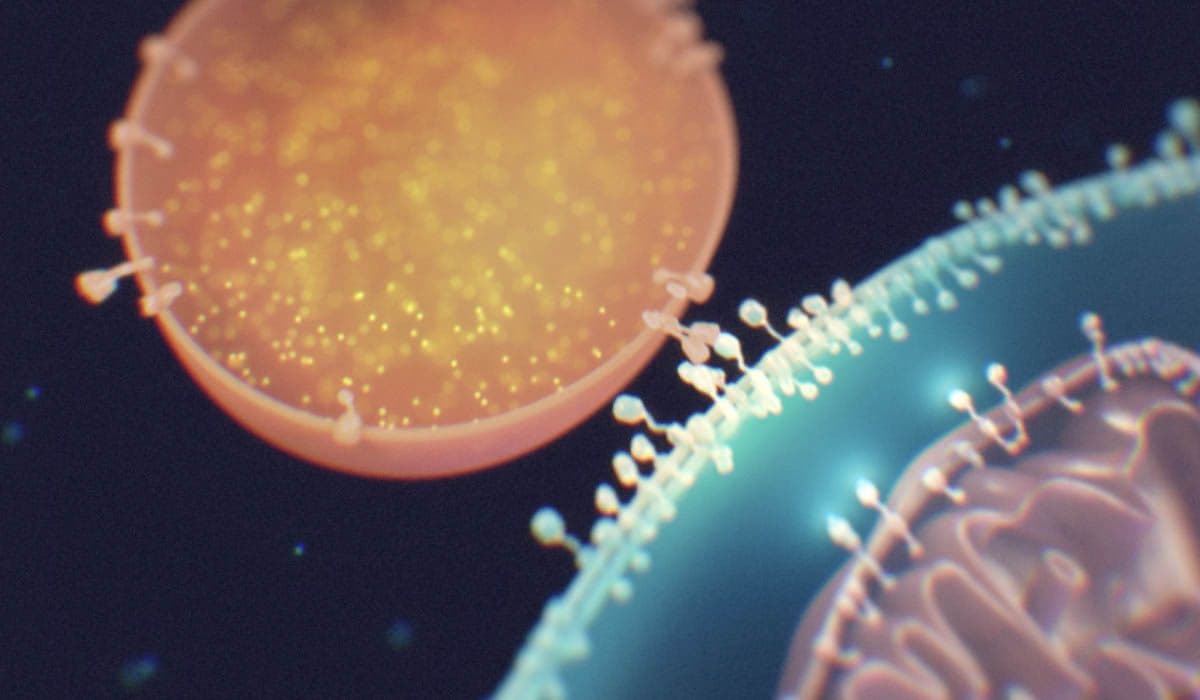
An image uploaded to Strapi called project_evandro-fang_hero

VITADAO RESEARCH
VITADAO RESEARCH
A global community on a mission to solve aging
VitaDAO unites talent, resources, and capital through a decentralized and transparent model that empowers individuals to drive innovation in aging research. We enable efficient capital allocation to early-stage biotech research projects and ensure that resulting intellectual property remains community-owned and equitably distributed.

WE OFFER a new model for funding, advancing and commercializing novel therapeutics in an equitable, Permissionless and democratic way.
LEARN HOW WE FUND
RESEARCH USING IPTs

FUNDING IRL
SCIENCE ONCHAIN
31
Projects
Funded
$4.7M
Funding
Deployed
$60.0M
Projects
FDV
3
Target
Discovery
Projects
18
Drug
Discovery
Projects
3
Preclinical
Drug Dev
Projects
3
Clinical
Drug Dev
Projects
8
IPTs
Generated
3
Companies
Founded
FUNDING IRL
SCIENCE – ONCHAIN
31
Projects
Funded
$4.7M
Funding
Deployed
$60.0M
Projects
FDV
3
Target
Discovery
Projects
18
Drug
Discovery
Projects
3
Preclinical
Drug Dev
Projects
3
Clinical
Drug Dev
Projects
8
IPTs
Generated
3
Companies
Founded
SCIENTIFIC ADVISORY BOARD

Aubrey de Grey
Biomedical Gerontologist

Jack Scannell
CEO of Etheros Pharmaceuticals Corp

Marco Quarta
Scientist, Entrepreneur, & Biotech Executive

Sebastian Brunemeier
Biotech VC & Company Builder

AUBRAI
On-chain AI Agent

working on the next longevity science breakthrough?
HOW VITADAO FUNDS RESEARCH WITH IPTS
An IPT (short for Intellectual Property Token) is a digital token that represents ownership, licensing rights, or financial interest in a specific piece of intellectual property—typically a patent, research asset, or therapeutic development—in a blockchain-based ecosystem.
In the context of VitaDAO, an IPT is used to:
- Tokenize early-stage biotech research so it can be transparently funded, governed, and commercialized by a decentralized community.
- Represent rights to IP, such as licensing revenue, equity in spin-outs, or downstream royalties.
- Enable fractional ownership, allowing multiple stakeholders—scientists, funders, and contributors—to participate in and benefit from the development of longevity-focused therapeutics.
- Align incentives by giving token holders governance power and economic interest in the success of the project.

VitaLabs incubates high-risk, high-reward longevity science by fully funding and de-risking bold early-stage research in-house—laying a strong scientific foundation before minting an IP token (IPT) to represent the resulting intellectual property.
For externally developed projects, VitaDAO takes a complementary approach: validated, late-stage innovations launch directly as IPTs, enabling the community to collectively fund their final push toward clinical translation and commercialization. This dual-track model ensures that both breakthrough discoveries and mature biotech assets receive the tailored support they need to reach the public.